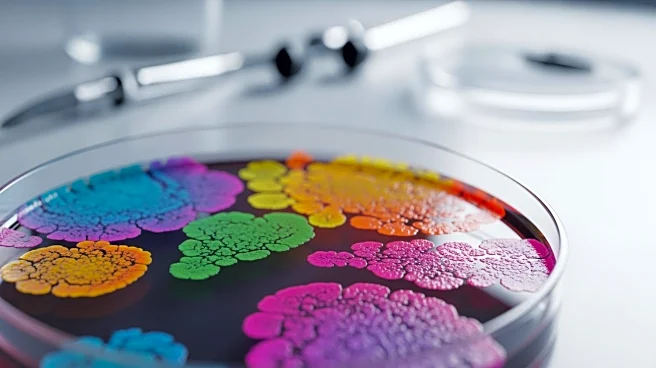
Harvard Study Identifies Gut Microbiome's Role in Metabolic Health

What's Happening?
A recent study has investigated the role of gut microbiota in influencing the metabolic response to exercise, particularly in individuals with overweight or obesity. The research, led by Aimin Xu, highlights
that not all individuals experience metabolic improvements from exercise, and this variability may be linked to the gut microbiota profile. The study aims to address how gut microbiota and microbial metabolites communicate with the human body to modulate exercise responsiveness, focusing on glycemic control and insulin sensitivity. This research builds on previous findings that identified a lack of metabolic response in some individuals during exercise interventions, suggesting a significant role of gut microbiota in these outcomes.
Why It's Important?
Understanding the gut microbiota's influence on exercise response could have significant implications for personalized medicine and public health strategies. By identifying individuals who may not benefit metabolically from exercise due to their gut microbiota profile, tailored interventions could be developed to enhance exercise efficacy. This could lead to more effective management of metabolic diseases such as type 2 diabetes mellitus, potentially reducing healthcare costs and improving patient outcomes. The study underscores the importance of considering individual biological differences in health interventions, which could lead to more personalized and effective treatment plans.